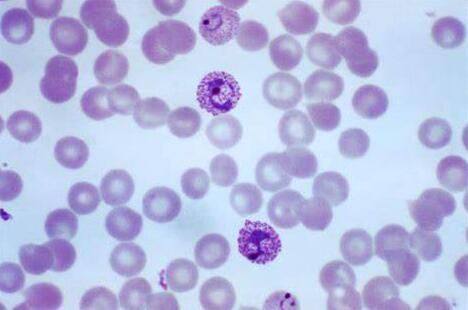

Nature:揭示药物互作机制 有望开发出新型抗疟疾疗法 |
 |
2020年2月7日 讯 /BIOON/ --结晶过程(crystallization)是药物开发、石化加工和其它工业活动的核心,但科学家们表示,目前他们仍在研究警惕形成和溶解过程中复杂的相互作用,近日,一项刊登在国际杂志Nature上的研究报告中,来自休斯顿大学等机构的科学家们通过研究首次在分子水平下阐明,当两种抑制晶体形成的化合物结合时会发生什么状况,比如抗疟疾药物等。
图片来源:de.wikipedia.org
研究者Jeffrey Rimer表示,你可能会认为使用两种以不同方式攻击结晶的药物会产生协同效应,或者至少是附加作用,但实际上,这两种药物就能够相互抵抗;对抗合作(antagonistic cooperation)意味着,两种药物联合使用的效果比单独使用差,文章中,研究人员希望能够设计出有效的疟疾疗法,当研究者对分子进行修饰后,他们发现,分子结构上的一个小变化就能够极大地改变其功能。
疟疾是一种蚊媒性疾病,2017年435,000人因感染疟疾而死亡,其是一种由寄生虫所引起的疾病,疟疾会消耗机体中的血红蛋白,并留下一种称之为血红素的化合物,而寄生虫会将这种化合物隔离在经体内,抗疟疾疗法就是通过抑制警惕的形成,释放血红素来攻击寄生虫。这项研究中,研究人员在四种抗疟疾药物的情况下对血红素晶体的形成进行了研究,这四种药物包括氯喹、奎宁、甲氟喹和阿莫地喹。
研究者Vekilov表示,通过使用原子力显微镜等实验,研究人员展示了通过两种不同机制攻击晶体形成的这些化合物在结合时的行为改变,这或许能帮助他们在分子水平下阐明抗疟疾的新思路和方向;相关研究结果或为科学家们寻找合适的抑制剂来控制晶体形成,从而有效抑制疟原虫生长提供新的思路。(100医药网100yiyao.com)
原始出处:
Wenchuan Ma, James F. Lutsko, Jeffrey D. Rimer, et al. . Nature, 2020; DOI: 10.1038/s41586-019-1918-4
医药网新闻
- 相关报道
-
- 2025年7月Science期刊精华 (2025-07-31)
- 事关产假、托育服务、住房支持等 育儿支持政策步伐一览 (2025-07-31)
- 育儿补助哪些人可以领?什么时分领?多部分回应 (2025-07-31)
- 国度医保局地下宣布第三批智能监管“两库”规定和常识点 (2025-07-31)
- 我国国民西医药安康文明素养程度达26.85% (2025-07-31)
- Nature Genetics:拨开百年迷雾!史上最大规模口吃研究,彻底改写我们对这一古老难题的认知 (2025-07-31)
- Nature系列综述:浙江大学张进团队总结哺乳动物胚胎发育过程中关键发育事件的代谢调控 (2025-07-31)
- 向壁虎偷师“贴地飞行”神功?Adv. Mater.: 仿壁虎脚的软树枝颗粒,让膀胱癌药物告别“短命”,显著抑制肿瘤生长并调动免疫 (2025-07-31)
- Environ Sci Technol:铀的同位素组成或可用于无创测量肾脏中铀的积累 (2025-07-31)
- Immunity:血液中的蛋白质可能有助于预测疟疾的严重程度 (2025-07-30)
- 视频新闻
-
- 图片新闻
-
医药网免责声明:
- 本公司对医药网上刊登之所有信息不声明或保证其内容之正确性或可靠性;您于此接受并承认信赖任何信息所生之风险应自行承担。本公司,有权但无此义务,改善或更正所刊登信息任何部分之错误或疏失。
- 凡本网注明"来源:XXX(非医药网)"的作品,均转载自其它媒体,转载目的在于传递更多信息,并不代表本网赞同其观点和对其真实性负责。本网转载其他媒体之稿件,意在为公众提供免费服务。如稿件版权单位或个人不想在本网发布,可与本网联系,本网视情况可立即将其撤除。联系QQ:896150040






















